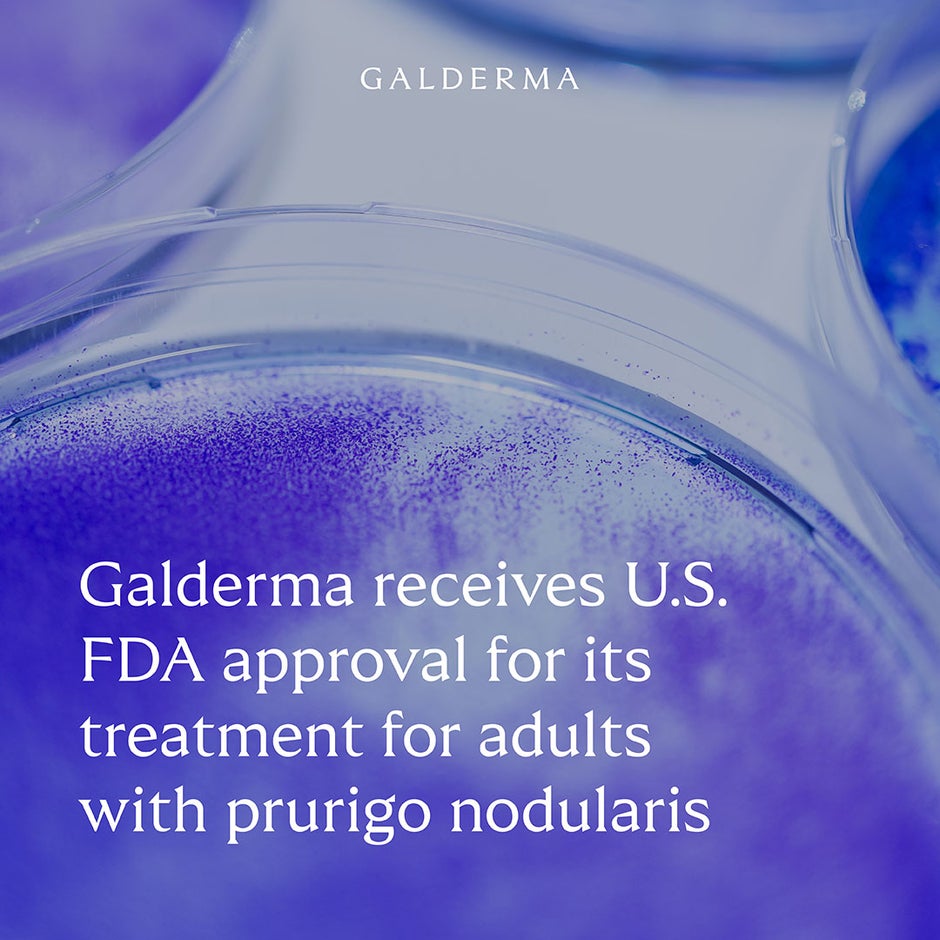

Galderma receives U.S. FDA approval for Nemluvio® (nemolizumab) for adult patients living with prurigo nodularis
Ad hoc announcement pursuant to Art. 53 LR
- Nemluvio® (nemolizumab) is the first approved monoclonal antibody specifically inhibiting the signaling of IL-31, a neuroimmune cytokine that drives multiple disease mechanisms in prurigo nodularis1-3
- Prurigo nodularis is a chronic skin condition that is estimated to affect up to 181,000 people in the United States, and is characterized by persistent, intense itch4-8
- The U.S. Food and Drug Administration granted Nemluvio Priority Review for the treatment of prurigo nodularis in February 2024, following its Breakthrough Therapy Designation in 2019
- Further marketing authorization applications are under regulatory review by multiple regulatory authorities, including the European Medicines Agency and Health Canada
Zug, Switzerland – August 13, 2024 – Galderma today announced that the U.S. Food and Drug Administration (FDA) has approved Nemluvio® (nemolizumab) as a pre-filled pen for subcutaneous injection for the treatment of adults with prurigo nodularis.1 Nemluvio was granted Breakthrough Therapy Designation in December 2019 and Priority Review in February 2024 by the U.S. FDA – a status reserved for medicines with the potential to significantly improve the treatment of serious conditions.
Prurigo nodularis is an underdiagnosed neuroimmune skin disease which is estimated to affect up to 181,000 people in the United States.7,8 This condition is characterized by several debilitating symptoms, including chronic itch, skin nodules covering large body areas, and poor sleep quality.5,9 Given the significant burden on patients, there is a need for alternative treatment options that may effectively relieve key signs and symptoms of the disease.10 Nemluvio specifically inhibits IL-31 cytokine signaling, which is known to drive itch and is involved in inflammation, altered epidermal differentiation, and fibrosis (hardening of skin tissue) in prurigo nodularis.1-3,11,12
“The U.S. FDA’s rapid approval of Nemluvio in prurigo nodularis is a first step in achieving its blockbuster platform potential and reinforces our leadership in therapeutic dermatology. We’re confident in the impact this first-in-class therapy will have for patients with prurigo nodularis who urgently need more treatment options and look forward to potentially bringing Nemluvio to patients with other itch-related skin diseases in the near future.”
FLEMMING ØRNSKOV, M.D., MPH
CHIEF EXECUTIVE OFFICER
GALDERMA
The approval is based on positive results from the phase III OLYMPIA clinical trials – the largest clinical trial program conducted in this condition to date – in which Nemluvio demonstrated significant and clinically meaningful improvements in itch and skin nodules at Week 16, with rapid reductions in itch observed as early as Week 4.1,13-16
The phase III OLYMPIA 1 and OLYMPIA 2 clinical trials evaluated the efficacy and safety of Nemluvio administered subcutaneously every four weeks in more than 500 patients with prurigo nodularis.13-16 The trials met both their primary and key secondary endpoints, demonstrating that:
- 56% and 49% of Nemluvio-treated patients in OLYMPIA 1 and 2 respectively, achieved at least a four-point reduction in itch intensity at Week 16, as measured by the peak-pruritus numerical rating scale, compared to 16% in both placebo groups (p<0.001) (primary endpoint).1
- 41% of Nemluvio-treated patients in OLYMPIA 1 and 2 achieved at least a four-point reduction in itch intensity at Week 4, as measured by the peak-pruritus numerical rating scale, compared to 6% and 7% in the placebo group (p<0.001) (key secondary endpoint).1
- 26% and 38% of Nemluvio-treated patients in OLYMPIA 1 and 2 respectively, reached clearance (investigator’s global assessment [IGA] 0) or almost-clearance (IGA 1) of skin nodules at Week 16, when assessed using the IGA score (range: 0-4), compared to 7% and 11% in the placebo group (p<0.001) (primary endpoint).1
- 50% and 52% of Nemluvio-treated patients in OLYMPIA 1 and 2 respectively, achieved at least a four-point reduction in sleep disturbance at Week 16, as measured by the sleep disturbance numerical rating scale, compared to 12% and 21% in the placebo group (p<0.001) (key secondary endpoint).15,16
The trials also met all other key secondary endpoints, confirming rapid reduction of itch due to prurigo nodularis, and sleep disturbance, within four weeks of treatment initiation.1,15,16 Nemluvio was generally well tolerated, and its safety profile was consistent with the phase II trial, and between the OLYMPIA 1 and 2 trials.1,15,16
“I’m delighted that Nemluvio has received U.S. FDA approval and I’m looking forward to offering this treatment option to the prurigo nodularis patients in my practice who are in desperate need of fast relief from itch, which negatively impacts their quality of life. By inhibiting the signaling of IL-31, Nemluvio addresses a key driver of prurigo nodularis, safely and effectively improving itch as well as skin nodules.”
Dr. SHAWN KWATRA, M.D.
LEAD INVESTIGATOR OF OLYMPIA PROGRAM
JOSEPH W. BURNETT ENDOWED PROFESSOR AND CHAIRMAN OF DERMATOLOGY UNIVERSITY OF MARYLAND SCHOOL OF MEDICINE
The U.S. FDA has also accepted for review the Biologics License Application for Nemluvio for the treatment of moderate-to-severe atopic dermatitis, with a decision anticipated later this year. Galderma’s marketing authorization applications for Nemluvio in both prurigo nodularis and atopic dermatitis are under review by multiple regulatory authorities, including the European Medicines Agency and Health Canada, as well as in Australia, Singapore, Switzerland, and the United Kingdom, via the Access Consortium framework. Further submissions to other regulatory authorities will continue throughout 2024.
Media can find more information about prurigo nodularis in this media toolkit, and can watch this video to find out more about the role of IL-31 in prurigo nodularis.
About Nemluvio® (nemolizumab-ilto)
Nemluvio® (nemolizumab-ilto) was initially developed by Chugai Pharmaceutical Co., Ltd. In 2016, Galderma obtained exclusive rights to the development and marketing of nemolizumab worldwide, except in Japan and Taiwan. In Japan, nemolizumab is marketed as Mitchga® and is approved for the treatment of prurigo nodularis, as well as pruritus associated with atopic dermatitis in pediatric, adolescent, and adult patients.
Important Safety Information
Indication: NEMLUVIO® (nemolizumab-ilto) is a prescription medicine used to treat adults with prurigo nodularis.
Do not take NEMLUVIO if you are allergic to nemolizumab-ilto or to any ingredients in NEMLUVIO. Before taking NEMLUVIO, tell your healthcare provider about all of your medical conditions, including if you:
- are scheduled to receive any vaccination. You should not receive a live vaccine right before or during treatment with NEMLUVIO.
- are pregnant or plan to become pregnant. It is not known whether NEMLUVIO will harm your unborn baby.
- are breastfeeding or plan to breastfeed. It is not known whether NEMLUVIO passes into your breast milk and if it can harm your baby.
Tell your doctor about all the medicines you take, including prescription and over-the-counter medicines, vitamins, and herbal supplements.
NEMLUVIO may cause serious side effects, including: allergic reactions (hypersensitivity). Stop using NEMLUVIO and tell your healthcare provider or get emergency help right away if you get any of the following symptoms:
- Breathing problems or wheezing
- Swelling of the face, lips, mouth, tongue, or throat
- Fainting, dizziness, feeling lightheaded
- Fast pulse
- Swollen lymph nodes
- Joint pain
- Fever
- Skin rash (red or rough skin)
- Nausea or vomiting
- General ill feeling
- Cramps in your stomach area
The most common side effects of NEMLUVIO include:
- Headache
- Skin rashes: eczema, atopic dermatitis (a type of eczema), and eczema nummular (eczema presenting as scattered circular patches)
These are not all of the possible side effects of NEMLUVIO. Call your doctor for medical advice about side effects. You may report side effects to the FDA at 1-800-FDA-1088.
Please see full Prescribing Information including Patient Information.
About the phase III OLYMPIA clinical trial program13-16
The OLYMPIA program included two identically designed, pivotal phase III clinical trials which enrolled 560 patients – OLYMPIA 1 and OLYMPIA 2. This is the largest clinical trial program conducted in prurigo nodularis to date, and the only program to include a long-term extension study.
These global, randomized, double-blind, placebo-controlled phase III clinical trials assessed the efficacy and safety of nemolizumab monotherapy compared with placebo in patients at least 18 years of age with moderate-to-severe prurigo nodularis over a 16- or 24-week treatment period for OLYMPIA 2 and OLYMPIA 1, respectively.
About prurigo nodularis
Prurigo nodularis is a chronic, debilitating, and distinct neuroimmune skin disease characterized by the presence of intense itch and thick skin nodules covering large body areas.5 It is an underrecognized and underdiagnosed skin condition, and while there are limited studies investigating its prevalence, current estimates indicate that up to 181,000 people are living with prurigo nodularis in the United States.3,7,8,17 The majority of patients report that the persistent itch negatively impacts their quality of life.18 Furthermore, the intense itch associated with prurigo nodularis results in significant sleep disturbance and further contributes to reduced quality of life.9,19
About Galderma
Galderma (SIX: GALD) is the pure-play dermatology category leader, present in approximately 90 countries. We deliver an innovative, science-based portfolio of premium flagship brands and services that span the full spectrum of the fast-growing dermatology market through Injectable Aesthetics, Dermatological Skincare and Therapeutic Dermatology. Since our foundation in 1981, we have dedicated our focus and passion to the human body’s largest organ – the skin – meeting individual consumer and patient needs with superior outcomes in partnership with healthcare professionals. Because we understand that the skin we are in shapes our lives, we are advancing dermatology for every skin story. For more information: www.galderma.com.
For further information:
|
Christian Marcoux, M.Sc. Chief Communications Officer christian.marcoux@galderma.com +41 76 315 26 50 |
Emil Ivanov Head of Strategy, Investor Relations, and ESG +41 21 642 78 12
|
|
Sébastien Cros Corporate Communications Director +41 79 529 59 85 |
Jessica Cohen Investor Relations and Strategy Director +41 21 642 76 43 |
References:
- Galderma data on file. Nemluvio U.S. Prescribing Information. 2024
- Silverberg JI, et al. Phase 2B randomized study of nemolizumab in adults with moderate-to-severe atopic dermatitis and severe pruritus. J Allergy Clin Immunol. 2020;145(1):173-182. doi:10.1016/j.jaci.2019.08.013
- Bewley A, et al. Prurigo Nodularis: A Review of IL-31RA Blockade and Other Potential Treatments. Dermatol Ther (Heidelb). 2022;12(9):2039–2048. doi:10.1007/s13555- 022-00782-2
- Huang AH, et al. Prurigo nodularis: epidemiology and clinical features. J Am Acad Dermatol. 2020;83(6):1559-1565. doi:10.1016/j.jaad.2020.04.183
- Pereira MP, et al. European Academy of Dermatology and Venereology European prurigo project: expert consensus on the definition, classification and terminology of chronic prurigo. J Eur Acad Dermatol Venereol. 2018;32(7):1059-1065. doi:10.1111/jdv.14570
- Ständer S, et al. IFSI-guideline on chronic prurigo including prurigo nodularis. Itch. 2020;5(4):e42. doi:10.1097/itx.0000000000000042
- Kwatra SG, et al. Prevalence of prurigo nodularis in the United States:, J Am Acad Dermatol Int. 2024. doi:10.1016/j.jdin.2023.12.013.
- Ständer S, et al. Prevalence of prurigo nodularis in the United States of America: A retrospective database analysis. J Am Acad Dermatol Int. 2021;2:28-30.
- Kwatra SG. Breaking the itch–scratch cycle in prurigo nodularis. N Engl J Med. 2020;382(8):757-758. doi:10.1056/NEJMe1916733
- Chisolm SS. A Review of the Current Management and Burden of Prurigo Nodularis in the United States. AJMC. 2023; 2023;29(suppl 5):S63-S72. Doi.org/10.37765/ajmc.2023.89366
- Gibbs BF, Patsinakidis N, Raap U. Role of the pruritic cytokine IL-31 in autoimmune skin diseases. Front Immunol. 2019;10:1383. doi:10.3389/fimmu.2019.01383
- Yaseen B, Lopez H, Taki Z, et al. Interleukin-31 promotes pathogenic mechanisms underlying skin and lung fibrosis in scleroderma. Rheumatology (Oxford). 2020;59(9):2625-2636. doi:10.1093/rheumatology/keaa195
- ClinicalTrials.Gov. A Study to Assess the Efficacy and Safety of Nemolizumab (CD14152) in Participants With Prurigo Nodularis (PN). Available online. Accessed August 2024
- ClinicalTrials.Gov. An Efficacy and Safety Study of Nemolizumab (CD14152) in Participants With Prurigo Nodularis. Available online. Accessed August 2024
- Ständer S, et al. Nemolizumab monotherapy improves itch and skin lesions in patients with moderate-to-severe prurigo nodularis: Results from a global phase 3 trial (OLYMPIA 1): Late breaking abstract presented at EADV 2023
- Kwatra SG, et al. Placebo-controlled phase III trial of nemolizumab in patients with prurigo nodularis. N Engl J Med. 2023;389:1579-89. doi: 10.1056/NEJMoa2301333
- Huang AH, et al. Real-world prevalence of prurigo nodularis and burden of associated diseases. J Invest Dermatol. 2020;140(2):480-483.e4 doi:10.1016/j.jid.2019.07.697
- Todberg T, et al. Treatment and burden of disease in a cohort of patients with prurigo nodularis: a survey-based study. Acta Derm Venereol. 2020;100(8):adv00119. doi:10.2340/00015555-3471
- Aggarwal P, et al. Clinical characteristics and disease burden in prurigo nodularis. Clin Exp Dermatol. 2021;46(7):1277-1284. doi:10.1111/ced.14722